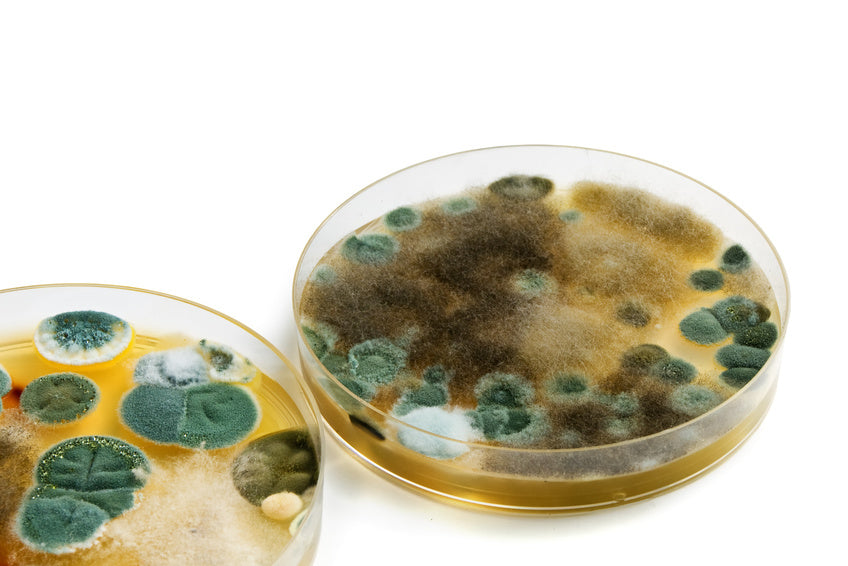

When it comes to juices, nothing is better that having them freshly made. An orange juice from freshly squeezed oranges is not only refreshing but is filled with essential vitamins, minerals and fiber. Not mentioning it saves tons of money at the grocery store and for sure a trip or 2 to the doctor.
Known in Venezuela as the "3-en-1" (three in one) the Orange, Carrot & Beet juice or smoothie, is wonderful to help lower your cholesterol, maintain healthy liver functions, while benefiting from its antioxidant properties.
Ingredients for 4 portions:
1 liter of freshly squeezed orange juice (avoid using bottled orange juice, is just not the same!).
1 small cooked or raw beet (personally I prefer the flavor of the cooked beet for this particular recipe)
1 small-medium carrot
If you like yours sweet, add 1 spoon of pure cane sugar or honey.
Peel and cut the beet into small pieces and cook in a pan covered with enough water until tender. Meanwhile squeeze the oranges. Wash the carrots, cut the ends but don't peel and slice them into small pieces (it is easier to juice them this way). In a blender add the beet, sliced carrots and the orange juice. Turn the blender or juicer on to medium or high. Blend until smooth. Strain to eliminate some of the unpleasant fiber if you don't like it. I prefer mine with all the fiber in it! Add the sugar cane or honey if you like it sweeter.
Drink in the morning or have it with some ice for a refreshing afternoon beverage.
Enjoy!
*Never store your juices or smoothies in the refrigerator. They oxidize loosing their nutritional value while changing their flavor.